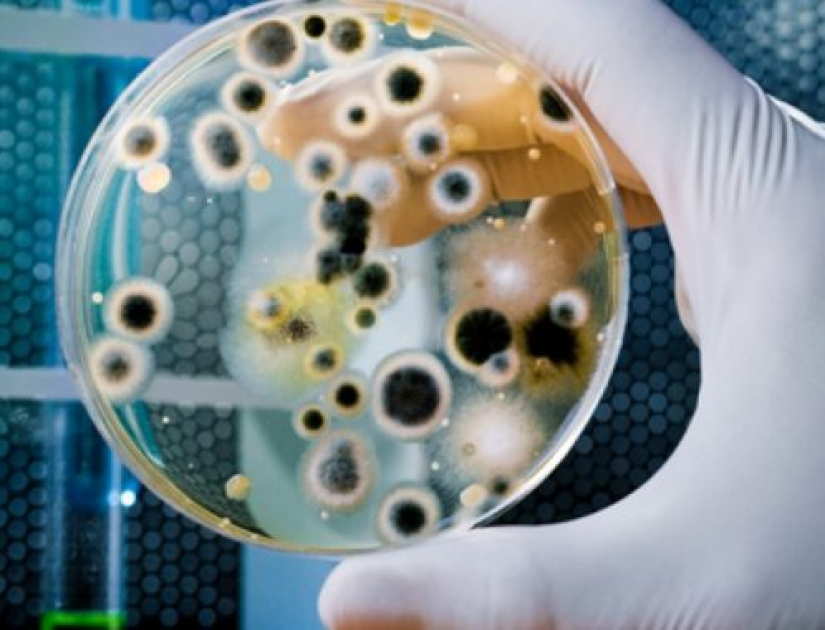

Grzybobranie - ciąg dalszy
W poprzednim tygodniu zacząłem nowy cykl poświęcony chorobom wywołanym przez ekspozycję na grzyby i pleśnie. W skrócie możemy powiedzieć, że nie wszystkie pleśnie są chorobotwórcze, a nawet te, które są potencjalnie chorobotwórcze nie zawsze muszą wywoływać choroby. Pleśniaki wydzielają chorobotwórcze toksyny, głównie w czasie stanów zagrożenia. Zwierzęta potrafią uciekać czy walczyć. Pleśnie mogą się bronić przez wydzielanie toksyn. Toksyny te mogą wpływać na różne systemy i organy powodując różne objawy i schorzenia, od trudnych do wyleczenia alergii, do chorób nowotworowych. O tym było w ostatnim artykule i postaram się je zamieścić na necie, ale o tym kiedy indziej. Skoro pleśnie mogą powodować różne schorzenia, mogą one być często mylone z innymi chorobami. I są to takie schorzenia jak: Fibromyalgia, Myalgic enephalomyelitis, Multiple chemical sensitivity, nietypową chorobę Alzheimera, chorobę Parkinsona, nietypowo przebiegające stwardnienie rozsiane (multiple sclerosis), astmę oskrzelową czy chroniczne zapalenie oskrzeli i rozedmę. Jak więc widać pacjent, który bezskutecznie leczy się na powyższe choroby może cierpieć na zespół związany z ekspozycją na pleśnie. Oczywiście bardzo często ekspozycja na toksyny pleśniakowe może być punktem wyjścia do innych zespołów chorobowych. Od pewnego czasu badaczy fascynuje fakt częstego współistnienia pleśniaków z boreliozą (Lyme disease). Okazuje się, że ludzie wyeksponowani na pleśnie znacznie częściej zapadają na boreliozę i wyeliminowanie z organizmu mykotoksyn (toksyny wydzielane przez pleśniaki) przyspiesza wyleczenie z borelizy. Czyli nie tylko kleszcze, ale i pleśnie. Innym zespołem chorobowym spowodowanym przez pleśnie może być tzw. Multiple Chemical Sensitity. I tu jest mały problem ponieważ mycotoksyny mogą usposabiać do nadmiernej wrażliwości na związki chemiczne, ale też mogą do złudzenia przypominać nadmierną wrażliwość. Mykotoksyny mogą też usposabiać do nadmiernej wrażliwości na działanie pola elektromagnetycznego. Dlatego często słyszymy, że pacjenta często boli głowa i źle się czuje po ogladaniu telewizji czy pracy przy komputerze. Ciekawym zespołem chorobowym jest tak zwany MCAS czyli szybka aktywacja tak zwanych mastocytów (komórek odpowiedzialnych za szybkie reakcje alergiczne), dlatego nagle u pacjenta pojawiają sie ciężkie alergie, takie jak niczym nie spowodowany atak świądu i pieczenia skóry, bóle gardla, zatok, nudności, wymioty. Zaburzeniom tym mogą towarzyszyć takie objawy jak palpitacje czy skurcze macicy i zaburzenia miesiączkowania. Chociaż już tu raz nadmieniałem mogą pojawić się objawy ze strony przewodu pokarmowego takie jak wzdęcia i niestrawność. Bardzo często pojawiają się zaburzenia ze strony układu nerwowego. Pacjent staje się nerwowy, agresywny lub wręcz przeciwnie depresyjny, płaczliwy. Innymi objawami spowodowanymi przez mykotoksyny mogą być objawy nietolerancji na niektóre leki – zwłaszcza sterydy, a zwłaszcza ze środków naturalnych glutationu. Z innych objawów mogą pojawić się „dziwne objawy” takie jak uczucie szoku elektrycznego, czy wręcz ukłucia przez kawałek lodu. Czasem pojawiają się parestezje, zaburzenia czucia wibracji.
Ciąg dalszy za tydzień.
Dr. Andrzej Salaniuk N.D.
Lakeshore Natural Health Clinic
1153 Glenashton Drive, Oakville,ON
416-830-0626
www.Facebook.com/Lakeshore Natural Health Clinic
Serwisy pokryte przez większość ubezpieczeń/benefity.
Możliwość bezpośredniego rozliczania z kompaniami ubezpieczeniowymi.
Gift certificates available.
Comment (0)